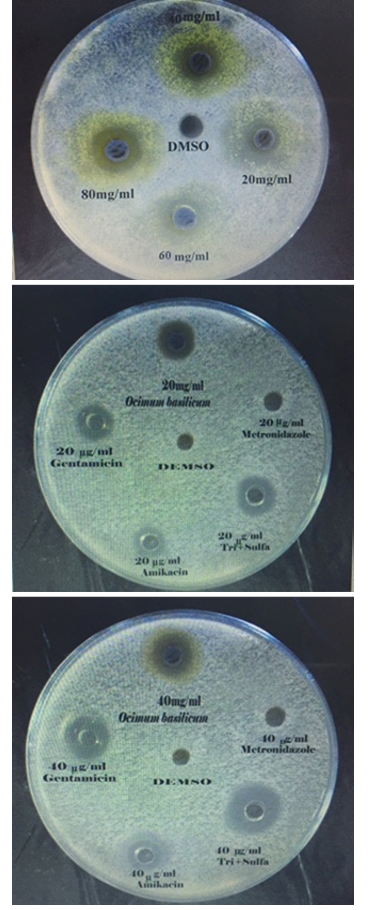

Advances in Animal and Veterinary Sciences
Research Article
Adv. Anim. Vet. Sci. 3 (6): 308 - 320
Figure 1
Sensitivity of E. coli to different concentrations of O.B extract and Antibiotics